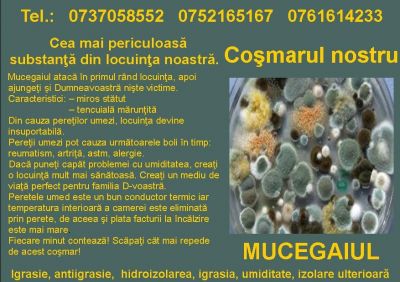

-
-
Tip anunt: Oferta
Stare produs: Nou
-
Igrasie, Antiigrasie, hidroizolarea Mold Removal, igrasia, umiditate, izolare ulterioară
Igrasie solutii.
Coşmarul nostru: MUCEGAIUL
Scăpaţi de igrasia pereţilor, de mucegai, de umiditatea nedorită!
Izolarea ulterioară a pereţilor cu igrasie
Pereţi umezi,azotos? Vopsea căzută?Tencuială mărunţită? Suprafeţe mucegăite? Miros neplăcut,stătut?
Uscarea pereţii economic
Mai mult decăt 48000 de clădiri ecologice în Europa.
Izolarea ulterioară a clădirilor umeziţi,azotos,mucegăit.
- Video:
-
Anunturi similare
-
-
Cofraje TEGO. Importator TEGO. Transport gratuit
Vindem placi TEGO, cu film fenolic 120g, la pret de importator direct. Avem preturi mici la TEGO. Grosimi TEGO: 4mm, 8mm,...
-
99,00
RON
- 10 Noiembrie 2025
-
-
Cofraje TEGO. Importator TEGO. Transport gratuit
Vindem placi TEGO, cu film fenolic 120g, la pret de importator direct. Avem preturi mici la TEGO. Grosimi TEGO: 4mm, 8mm,...
-
99,00
RON
- 13 Octombrie 2025
-
-
Pavele si dale din cauciuc
Ideal pentru amenajare locuri de joaca pentru copii (parcuri, gradinite, scoli, case), terase circulabile, balcoane, alei...
-
89,00
RON
- 30 Septembrie 2025
-
Cele mai citite
-
-
Piatra naturala placare gard, soclu, fatada Rocas Decor...
Piatra naturala Rocas Decor este culeasa din toate colturile lumii. Importam piatra naturala sub diferite forme: granit,...
- 14 Mai 2013
-
-
Placare, blaturi, baie travertin Rocas Decor
Travertinul este unul din produsele noastre de baza si de-a lungul timpului am devenit experti in acest domeniu. La noi veti...
- 14 Mai 2013
-
-
Piatra naturala placare soclu, gard, fatada Rocas Decor...
Piatra naturala Rocas Decor este culeasa din toate colturile lumii. Importam piatra naturala sub diferite forme: granit,...
- 27 Septembrie 2012
- Formular de contact
-
Comentarii
-
Spune-ne parerea ta despre anuntul "Mold Removal, Igrasie, igrasia, umiditate, izolare ulterioară, hidroizolarea, antiigrasie".
-